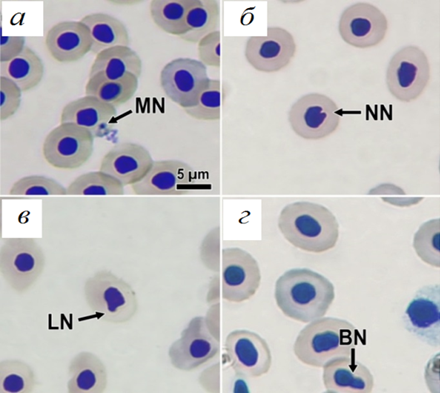

Россия
Россия
Россия
Россия
Россия
Экстракты бурых макроводорослей широко применяют в фармакологии, косметологии и пищевой промышленности, однако добыча сырья, с одной стороны, подрывает природные популяции, а с другой – при плантационном их выращивании является дорогостоящим производством. В качестве перспективного объекта для приготовления экстрактов рассматривается нитчатая быстрорастущая водоросль Laminariocolax aecidioides. Предполагается использовать данный экстракт в качестве биологически актив-ной добавки при кормопроизводстве для индустриальной аквакультуры и поэтому очень важно проверить его токсичность на клетки прокариот и эукариот. Действие экстракта на прокариотические клетки было оценено с помощью lux-биосенсоров Escherichia coli К12 MG1655 (pColD-lux – повреждение ДНК и pSoxS-lux – развитие окислительного стресса), а эукариотические клетки – методом регистрации ядерных аномалий в крови костных рыб (микроядерный тест). Тестирование проводилось на сеголетках африканского клариевого сома, перспективного объекта индустриальной аквакультуры. Выявлено, что экстракт бурой водоросли L. aecidioides напрямую не повреждал ДНК и не вызывал окислительный стресс, но вызывал гибель бактериальных клеток в высоких концентрациях (50 и 100 %), при этом результаты микроядерного теста показали отсутствие токсического воздействия экстракта во всех вариантах опыта на эукариотические клетки крови Clarias gariepinus, частота микроядер не превышала 1,5 ‰. Количество микроядер может достигать значений 30 ‰ на фоне отсутствия генотоксического эффекта, поэтому можно предположить, что диапазон встречаемости микроядер в эритроцитах сомов, принятый за отсутствие генотоксического эффекта, составляет 0–30 ‰ на 1 000 клеток крови.
экстракт, lux-биосенсоры, pColD-lux, pSoxS-lux, бурые водоросли, Laminariocolax aecidioides, генотоксичность, окислительный стресс, микроядерный тест, ядерные аномалии
Введение
Согласно технологии получения водных экстрактов из бурых водорослей в их вытяжке содержится целый комплекс биологически активных веществ (БАВ): фукоидан, ламинаран, альгиновая кислота, маннит, йод, минеральные вещества [1, 2], флоротаннины [3].
Ламинаран стимулирует врожденный иммунитет у животных [4], обладает противоопухолевой и антиоксидантной активностью (эффективно инактивирует свободные радикалы), оказывает ингибирующее действие на бактерии [5], участвуя в индукции генов, кодирующих различные белки, связанные с патогенезом и антимикробными свойствами [6, 7]. Фукоидан ингибирует формирование гидроксильных и супероксидных радикалов [8], проявляет антиопухолевую [9] и антибактериальную активность [10]. Флоротаннины – фенольные метаболиты только бурых водорослей – имеют полимерную структуру, хорошо растворяются в воде, прочно связываются с биополимерами, хелатируют двухвалентные металлы – проявляют антиоксидантную активность [11].
Экстракты бурых водорослей широко применяют в фармакологии, косметологии и пищевой промышленности. В проведенных исследованиях они были рассмотрены в качестве биологически активных добавок при кормопроизводстве для индустриальной аквакультуры. До настоящего времени российская аквакультура ориентировалась на импорт европейских комбикормов, премиксов, компонентов кормов (рыбная мука, жиры), витаминов и ферментов. Однако интенсивные темпы развития рыбоводства в России диктуют необходимость развивать кормопроизводство на основе отечественного сырья, разрабатывать рецептуры всей линейки кормов – от стартовых до продукционных [12]. Было предположено, что экстракты бурых водорослей по своим свойствам могут играть роль кормовых добавок для повышения выживаемости молоди и увеличения продукционных показателей рыб.
Для получения экстрактов в промышленных масштабах используют крупные талломы водоросли из порядков Laminariales (Laminaria digitata и Saccharina latissima) и Fucales (Fucus vesiculosus), что требует значительных затрат на их плантационное выращивание или сбор растений из природных популяций, приводит к негативным экологическим последствиям для водорослевых сообществ [13]. Однако недавнее исследование А. В. Скрипцовой показало, что перспективным сырьем для получения необходимого количества БАВ нужного качества могут быть нитчатые бурые водоросли из порядка Ectocarpales рода Streblonema [14]. В этом случае появляется возможность выращивать водоросли в промышленном масштабе в биореакторах и получать БАВ за короткий срок и с наименьшими финансовыми затратами.
Среди нитчатых представителей порядка Ectocarpales наибольший интерес для получения БАВ при культивировании в биореакторах представляет морская эндофитная водоросль Laminariocolax aecidioides. Данный вид известен как паразит ламинариевых плантаций, вызывающий морфологические аномалии у своего хозяина (темные пятна на пластине, деформации пластины и стволика) и снижающий качество продукции; при этом он встречается повсеместно в северном полушарии [15].
Получение БАВ водорослевого происхождения из нетрадиционного сырья требует тщательной проверки его на биологическую безопасность, при этом важно понимать действие этих веществ на прокариотические и эукариотические клетки в отдельности. Как правило, влияние токсинов проявляется в повреждении ДНК клеток или развитии процессов окислительного стресса [16].
Действие различных токсинов на прокариотические клетки сейчас часто оценивают с помощью lux-биосенсоров – генетически модифицированных бактерий вида Escherichia coli штамма К12, содержащих рекомбинантные плазмиды с lux-опероном люминесцирующей бактерии Photorhabdus luminescens, слитым с промоторами генов супероксиддисмутазы soxS (pSoxS-lux), колицина-D cda (pColD-lux) и др. Интенсивность люминесценции этих штаммов позволяет быстро регистрировать про- и актиоксидантную активность (окислительный стресс), индукцию SOS-ответа при повреждении или остановке синтеза ДНК (генотоксичность) у прокариот [17, 18].
Комплексный ответ на токсины у рыб (повреждение ДНК эукариотических клеток, окислительный стресс и др.) недавно было предложено оценивать с помощью модификации микроядерного теста, где помимо частоты встречаемости микроядер учитывалось появление различных ядерных аномалий в эритроцитах рыб вида Danio rerio [19]. Так как предполагается использовать проверяемый экстракт бурых водорослей в качестве компонента кормов для индустриальной аквакультуры, микроядерный тест и, соответственно, действие экстракта на эукариотические клетки были проведены на особях африканского клариевого сома (Clarias gariepinus), выращиваемых в установках замкнутого водоснабжения (УЗВ). Следует отметить, что возможность изучения появления микроядер
в эритроцитах непосредственно на востребованных объектах аквакультуры, таких как африканский клариевый сом Clarias gariepinus, толстоголовый гольян Pimephales promelas и радужная форель Oncorhynchus mykiss, была показана ранее многими исследователями при проверке кормовых добавок на генотоксичность. В связи с этим установлено, что регистрация микроядер, а также других ядерных аномалий (модификация микроядерного теста) при использовании экстракта Laminariocolax aecidioides в качестве кормовой добавки для африканского клариевого сома позволит оценить его действие на эукариотические клетки.
Таким образом, целью данного исследования было тестирование водного экстракта эндофитной водоросли Laminariocolax aecidioides на генотоксичность и развитие окислительного стресса в клетках прокариотических и эукариотических клеток с помощью lux-биосенсоров и микроядерного теста соответственно.
Материалы и методы
Объект исследования. Морская эндофитная нитчатая бурая водоросль вида Laminariocolax aecidioides (Морской биобанк РК ННЦМБ ДВО РАН, регистрационный номер 506171) была выделена из талломов бурой водоросли Undaria pinnatifida в июне 2018 г. (залив Петра Великого, Японское море, Россия) и предоставлена для изучения сотрудниками ФГБУН Национального научного центра морской биологии им. А. В. Жирмунского Дальневосточного отделения Российской академии наук [15]. В настоящее время водоросль содержится в биоресурсной коллекции факультета биотехнологий и рыбного хозяйства ФГБОУ ВО «Московский государственный университет технологий и управления имени К. Г. Разумовского (Первый казачий университет)» (МГУТУ им. К. Г. Разумовского (ПКУ)). Условия выращивания: температура 10 ºС, освещенность 25 мкмоль/м–2 с–1, фотопериод L : D = = 12 : 12, еженедельная смена искусственной морской среды (обогащенная ES).
Приготовление экстракта. Свежие водоросли L. aecidioides экстрагировали дистиллированной водой (водоросли – дистиллированная вода, 1 : 5 г/мл) в течение 8 ч при комнатной температуре, нагревали до 80 ºС и выдерживали в течении 30 мин. Полученный горячий экстракт фильтровали и охлаждали по методике Л. Х. Вафиной, А. В. Подкорытовой [2].
В экспериментах использовали неразведенный экстракт, приняв его за 100 % (100 мл). Для получения конечных разведений 100 %-й экстракт разводили дистиллированной водой до концентраций 50; 10; 0,1 и 0,01 %.
Lux-биосенсоры. В исследовании были использованы два lux-биосенсора на основе штамма E. coli К12 MG1655: pColD-lux и pSoxS-lux, несущие рекомбинантную плазмиду с lux-опероном (luxCDABE) люминесцирующей морской фотобактерии Photorhabdus luminescens, транскрипционно слитой с промоторами генов колицина colD (cda) и супероксиддисмутазы soxS соответственно. Экспрессия lux-оперона в живых клетках E. coli приводит к биолюминесценции, интенсивность которой фиксировалась в ходе эксперимента.
Биосенсор pColD-lux люминесцирует в ответ на повреждение или остановку синтеза ДНК, т. е. характеризует уровень SOS-ответа бактерий на генотоксическое воздействие [17]. Интенсивность люминесценции биосенсора pSoxS-lux напрямую зависит от количества супероксид-анион-радикала, инициирующего развитие окислительного стресса в клетках [18].
Биосенсоры предоставлены Г. Б. Завильгельским и И. В. Мануховым (ФГБУ «Государственный научно-исследовательский институт генетики и селекции промышленных микроорганизмов Национального исследовательского центра ''Курчатовский институт''», г. Москва), их генотипы приведены в статье В. Ю. Котовой с коллегами [16].
Культивирование бактерий производилось на жидкой среде Луриа-Бертани (LB), содержащей ампициллин в концентрации 100 мкг/мл. Для проведения экспериментов использовали ночные культуры биосенсоров pColD-lux и pSoxS-lux, которые инкубировали в течение 12 ч при 37 ºС. Перед применением культуры биосенсоров pColD-lux и pSoxS-lux разводили свежей питательной средой LB до концентрации 107 мкл/мл, используя для коррекции денситометр DEN-1B (Biosan), и выращивали с аэрацией при 37 ºС до ранней экспоненциальной фазы в течение 2 ч.
Оценка генотоксического действия экстракта с помощью lux-биосенсоров. Ночные культуры бактерий переносили по 180 мкл в стерильные ячейки 96-луночных планшетов, в которые добавляли по
20 мкл тестируемого экстракта в концентрациях 100; 50; 10; 0,1 и 0,01 %. В качестве положительного контроля использовали диоксидин (0,001 моль/л) или паракват (0,0004 моль/л), в качестве отрицательного – дистиллированную воду. Диоксидин (1,4-диоксид 2,3-хиноксалиндиметанол, C10H10N2O4, «Новосибирскфарма») выбран в качестве положительного контроля, т. к. индуцирует SOS-ответ у био-сенсора pColD-lux и является мутагеном, индуцирующим хромосомные аберрации. Паракват (N,N'-диметил-4,4'-дипиридилиум дихлорид (C12H14Cl2N2, Sigma, USA)) индуцирует окислительный стресс
в клетках живых организмов и регистрируется биосенсором pSoxS-lux, играя роль положительного контроля [18].
Экспериментальные планшеты инкубировали в термостате при 37 ºС в течение 90 мин. Люминесценцию регистрировали с помощью микропланшетного ридера Stat-Fax 4400, Awareness Technology Inc. (США). Интенсивность биолюминесценции выражали в относительных единицах светового потока (отн. ед.). Каждый из двух экспериментов на выбранных биосенсорах проводили 3 раза в 8-ми повторностях. Схема эксперимента представлена на рис. 1, а.

Рис. 1. Схема изучения с помощью lux-биосенсоров
токсического действия экстракта из бурой водоросли Laminariocolax aecidioides на прокариотические клетки Esсherichia coli (а) и оценки их выживаемости (б)
Fig. 1. Scheme of studying the toxic effect of the extract brown alga Laminariocolax aecidioides
on Escherichia coli prokaryotic cells (a) and assessing their survival (б) with using lux biosensors
Оценка выживаемости бактерий Esсherichia coli. К 2 мл разведенной ночной культуры каждого биосенсора pColD-lux и pSoxS-lux в ранней экспоненциальной фазе добавляли по 200 мкл экстракта
в концентрациях 100; 50; 10; 0,1; 0,01 % дистиллированной воды (отрицательный контроль), диоксидина или параквата (положительный контроль) и инкубировали в течение 90 мин при 37 ºС. Суспензии бактерий серийно разводили в миллион раз в физиологическом растворе во всех вариантах опыта и высеивали по 100 мкл в чашки Петри с агаризованной питательной средой LB. Через 18 ч инкубации при 37 ºС подсчитывали число бактериальных колоний в каждой чашке Петри. Схема эксперимента по определению выживаемости графически представлена на рис. 1, б. Для оценки уровня SOS-ответа выживших бактерий рассчитывали удельную интенсивность биолюминесценции одной колониеобразующей единицы (Lv) в данном варианте опыта и умножали на 1 000, чтобы полученные значения легко интерпретировались:
![]()
где Lо – интенсивность люминесценции биосенсора опытной группы, отн. ед. (относительные условные единицы); No – число колониеобразующих единиц биосенсора, КОЕ. Все эксперименты проводили 3 раза в 3-х независимых повторностях.
Оценка генотоксического действия экстракта на эукариотические клетки. В качестве тест-объекта были взяты особи африканского клариевого сома (Clarias gariepinus).
Экспериментальный рацион. За основу рациона были взяты два коммерческих комбикорма Coppens (Нидерланды): тонущий гранулированный комбикорм Coppens Intensiv (3 мм) и Coppens Suprime-21 (4,5 мм).
Приготовленный ранее экстракт из L. aecidioides вводили в опытные корма путем распыления его по поверхности кормовых гранул и высушивания их при температуре 40 °С до первоначальных значений влажности. Подготовленные гранулы хранили в герметичном контейнере при температуре 4 ºС и использовали их за одну неделю. Для напыления брали различные концентрации экстракта из расчета 5 мл 100 % экстракта на 95 г корма – 5 % и 15 мл 100 % экстракта на 85 г корма – 15 %. Контрольную группу сомов кормили кормом без экстракта.
Схема эксперимента. Сеголетки африканского клариевого сома (Clarias gariepinus) (18,2 ± 2 г) выращивались в экспериментальных группах по 10 особей в емкостях 140 × 110 × 90 см (1 000 л) в УЗВ (pH = 7,5–7,6; T = 25 ºС; L : D = 12 : 12).
После недельной акклиматизации были сформированы 3 опытные группы сомов по 10 особей: контроль (корм без добавления экстракта), группа 5 % и группа 15 % (кормили с добавлением 5 и 15 % экстракта соответственно). Объем корма рассчитывался от биомассы рыб в УЗВ и составлял 4 %, поэтому объем корма корректировался по мере роста рыб. Всех рыб кормили 2 раза в сутки: в 10:00
и 18:00. Продолжительность эксперимента составила 60 сут.
Микроядерный тест. Микроядерный тест проводили в первый и последний день эксперимента. В указанные сроки из каждой исследуемой группы отбирали по 3 особи сомов одного размера, без видимых повреждений, анестезировали гвоздичным маслом в концентрации 0,05 % и отбирали из хвостовой вены образцы крови (1 мл).
Мазки крови изготавливались по стандартной методике [19]. Препарат крови высушивался на воздухе в течение 2–3 мин, далее фиксировался в смеси Никифорова (1 : 1 метиловый спирт : диэтиловый эфир) в течение 20 мин. Затем его окрашивали азур-эозином по Романовскому – Гимзе, для чего в 190 мл буферного раствора (pH = 7,0) добавляли 9 мл красителя, окрашивали препараты в течение 10 мин, затем трижды промывали дистиллированной водой и высушивали в стерильных условиях в течение 30 мин. Препараты просматривались под световым микроскопом Olympus BX53 (Olympus Corporation, Япония) с окулярной приставкой Carl Zeiss ERc 5s (Zeiss, Германия).
Частота встречаемости микроядер и ядерных аномалий в эритроцитах Clarias gariepinus определялась согласно методике [19]. Частота встречаемости микроядер, принятая как генотоксический эффект на модели Danio rerio, составляет 5 ‰ на 1 000 клеток крови. Помимо микроядер (MN) учитывались следующие аномалии ядер: notched nuclei («деформированное ядро» – NN), lobbed nuclei («разрезанное ядро» – LN) и blebed nuclei («прикрепленное ядро» – BN).
Статистический анализ данных производился с использованием GraphPad Prism version 9.0 software (GraphPad, San Diego, CA, USA). Перед статистическим анализом все данные были проверены на нормальность распределения с помощью теста Колмогорова – Смирнова. Признаком достоверности индукции люминесценции считали статистически значимое превышение Lo над Lk, оцениваемое по t-критерию Стьюдента для независимых переменных, где Lk – интенсивность люминесценции контрольной пробы (в отн. ед.). Для всех данных рассчитывались среднее значение и стандартное отклонение.
Результаты
Действие экстракта на прокариотические клетки. Биосенсор pColD-lux. Относительная люминесценция при высоких (50 и 100 %) концентрациях экстракта снижалась и была ниже значений отрицательного контроля (К–) в 0,8 и 1,2 раза соответственно, тогда как люминесценция положительного контроля (диоксидина) была выше отрицательного в 27 раз (табл. 1).
Таблица 1
Table 1
Влияние экстракта Laminariocolax aecidioides на люминесценцию биосенсора pColD-lux
Effect of Laminariocolax aecidioides extract on the luminescence of the pColD-lux biosensor
|
Вариант опыта* |
Количество КОЕ, ´ 106 |
Lо, отн. ед. |
Lv, отн. ед. |
|
К– |
92 ± 13 |
1 348 ± 93 |
0,015 ± 0,002 |
|
0,01 |
88 ± 6 |
1 389 ± 55 |
0,016 ± 0,0012 |
|
0,1 |
80 ± 4 |
1 367 ± 93 |
0,017 ± 0,0005 |
|
10 |
83 ± 6 |
1 299 ± 52 |
0,015 ± 0,0005 |
|
50 |
59 ± 14** |
1 209 ± 51** |
0,02 ± 0,002** |
|
100 |
33 ± 8** |
1081 ± 55** |
0,035 ± 0,004** |
|
К+ |
1 ± 0** |
36 516 ± 3 551** |
35,97 ± 3,36** |
* «К–» – отрицательный контроль (дистиллированная вода), «К+» – положительный контроль (паракват); ** значения, достоверно отличающиеся от отрицательного контроля.
Следует отметить, что уменьшение биолюминесценции бактерий при 50 и 100 % экстракта сопровождалось снижением в 2 раза выживаемости прокариотических клеток биосенсоров.
Расчет удельной люминесценции на 1 000 жизнеспособных бактерий (Lv) показал увеличение в 1,4 и 2,2 раза данного показателя в рассматриваемых вариантах опыта относительно отрицательного контроля, что говорит об увеличении SOS-ответа и повреждении ДНК в выживших клетках. Однако непосредственное разрушение ДНК диоксидином давало превышение значений удельной люминесценции на 3 порядка относительно отрицательного контроля, следовательно, можно утверждать, что экстракт не повреждал непосредственно ДНК клеток (нет генотоксического эффекта) и механизм его подавления бактериальных клеток другой.
Биосенсор pSoxS-lux. Относительная люминесценция биосенсора pSoxS-lux при воздействии экстракта водоросли в концентрации 50 и 100 % была соответственно в 2 и 3 раза ниже по сравнению
с отрицательным контролем (табл. 2), тогда как паракват (положительный контроль), напротив, усиливал люминесценцию тест-системы почти в 2 раза.
Таблица 2
Table 2
Влияние экстракта Laminariocolax aecidioides на люминесценцию биосенсора pSoxS-lux
Effect of Laminariocolax aecidioides extract on the luminescence of the pSoxS-lux biosensor
|
Вариант опыта |
Количество КОЕ, ´ 106 |
Lо, отн. ед. |
Lv, отн. ед. |
|
К– |
114 ± 26 |
2 898 ± 97 |
0,024 ± 0,002 |
|
0,01 |
128 ± 19 |
3 028 ± 90 |
0,023 ± 0,002 |
|
0,1 |
118 ± 16 |
3 102 ± 69 |
0,026 ± 0,001 |
|
10 |
84 ± 27 |
2 696 ± 25 |
0,034 ± 0,004* |
|
50 |
40 ± 13* |
1 243 ± 62* |
0,034 ± 0,005* |
|
100 |
24 ± 6* |
903 ± 55* |
0,038 ± 0,003* |
|
К+ |
1 ± 0* |
5 304 ± 707* |
5,3042 ± 0,4* |
* Значения, достоверно отличающиеся от отрицательного контроля.
Выживаемость бактерий в вариантах опыта 50 и 100 % была примерно в 3 и 5 раз ниже, чем в отрицательном контроле, но выше, чем при воздействии параквата. Выжившие после обработки водорослевыми экстрактами (10, 50 и 100 %) бактерии проявляли очевидные сигналы окислительного стресса. Уровень pSoxS-люминесценции у них был в 1,5 раза выше, чем в отрицательном контроле, и на 2 порядка ниже при действии параквата.
Действие экстракта L. aecidioides в отношении эукариотических клеток. Выраженных аномалий эритроцитов клеток крови сомов не наблюдалось при добавлении исследуемых концентраций экстракта. Количество микроядер на первые сутки эксперимента у всех особей Clarias gariepinus в эксперименте было в пределах нормы, т. е. ниже 5 ‰ на 1 000 клеток крови (табл. 3).
Таблица 3
Table 3
Соотношение эритроцитарных ядерных аномалий на 1 000 клеток крови Clarias gariepinus, ‰
Ratio of erythrocyte nuclear anomalies per 1000 Clarias gariepinus blood cells
|
Сутки |
Вариант опыта |
MN |
NN |
LN |
BN |
TNA* |
|
0 |
Контроль |
0,87 ± 1,52 |
7,67 ± 9,36 |
1,42 ± 1,33 |
3,29 ± 3,66 |
13,27 ± 10,48 |
|
5 % |
1,24 ± 1,39 |
0,91 ± 1,58 |
0,72 ± 1,26 |
0,72 ± 1,26 |
3,62 ± 2,34 |
|
|
15 % |
0 |
8,17 ± 4,90 |
0 |
4,30 ± 7,46 |
12,48 ± 7,59 |
|
|
60 |
Контроль |
0 |
0,91 ± 1,58 |
0,91 ± 1,58 |
0,91 ± 1,58 |
2,74 ± 4,76 |
|
5 % |
0 |
1,39 ± 2,40 |
1,15 ± 2,00 |
0 |
2,54 ± 2,23 |
|
|
15 % |
0 |
1,79 ± 1,57 |
0,81 ± 1,40 |
0,81 ± 1,40 |
3,41 ± 3,66 |
* TNA – общее число ядерных аномалий.
Общее число ядерных аномалий (TNA) варьировало от 0 до 25 ‰. Высокие значения этого показателя обусловлены большим числом деформированных (NN – около 8 ‰) и прикрепленных (BN – около 4 ‰) ядер. Типы ядерных нарушений, обнаруженных нами в эритроцитах сомов, представлены на рис. 2.
Рис. 2. Ядерные аномалии эритроцитов
в крови C. gariepinus: MN – микроядро (а); NN – деформированное ядро (б);
LN – разрезанное ядро (в); BN – прикрепленное ядро (г)
Fig. 2. Erythrocytes nuclear anomalies
of C. gariepinus blood: MN – micronucleus (а); NN – notched nuclei (б); LN – lobbed nuclei (в);
BN – blebed nucle (г)
Через 60 сут эксперимента общее число ядерных аномалий достоверно снизилось во всех вариантах опыта и колебалось от 0 до 7 ‰, включая снижение числа деформированных ядер (около 1–2 ‰) и прикрепленных ядер (до 1 ‰), а микроядер не было обнаружено ни в одном варианте опыта.
Комплексного токсического действия экстракта, выражающегося в появлении ядерных аномалий эритроцитов рыб, не выявлено.
Обсуждение
Результаты исследования показали, что экстракт из L. aecidioides напрямую не повреждает ДНК
и не индуцирует окислительный стресс Escherichia coli, но в концентрации 50 и 100 % вызывает гибель бактериальных клеток. Это свидетельствует о том, что механизм воздействия экстракта на бактерии
не связан с непосредственным разрушением биополимеров. Например, согласно данным Bernard Fritig и др. [6] и L. C. van Loon, E. A. van Strien [7], ламинаран высших растений (1,3/1,6-β-D-глюкан) может участвовать в процессах регуляции экспрессии генов специфических белков, связанных с иммунной системой, тем самым повышая устойчивость растений к болезням. А исследования Jin Cai с коллегами [11] показали, что фукоиданы проявляют свою антибактериальную активность за счет хелатирования катионов металлов в структуре мембран клеточных стенок бактерий, что приводит к уменьшению их стабильности. Вероятно, экстракт Laminariocolax aecidiodes демонстрирует выраженный антибактериальный эффект за счет прямого действия на мембраны бактерий.
Микроядерный тест не выявил генотоксического действия экстракта, т. к. уровень микроядерных аномалий не превышал 5 ‰ на 1 000 клеток крови. Высокие показатели других ядерных аномалий
в начале эксперимента и низкие во всех вариантах опыта в конце исследования (см. табл. 3), вероятно, говорят о содержании сомов в недостаточно благоприятных для них условиях освещения в начале эксперимента. В литературе по разведению сомов ранее не указывались условия освещения, но, по рекомендации ихтиологов Центра «Аквакультура» МГУТУ им. К. Г. Разумовского (ПКУ), емкости
с сомами в первые сутки эксперимента были накрыты затеняющей сеткой. В результате освещенность была на уровне 2–8 мкмоль/м–2·с–1 (150–600 люкс), что положительно отразилось на состоянии сомов. Интересно, что многие исследователи указывали, что интенсивность эритропоэза у рыб (Oncorhynchus mykiss, Salmo gairdneri, Clarias batrachus) может зависеть от условий содержания [20]. Так, количество эритроцитов у костистых рыб зависит от температуры воды, концентрации кислорода, качества кормов, а также от условий транспортировки (у Cyprinus carpio) и высокой плотности посадки (у Sparus aurata), но не от уровня освещения. Количество всех зафиксированных ядерных аномалий в начале исследования, вероятно, следует отнести к нормальным показателям, т. к. особи африканского клариевого сома активно поглощали корм и не имели никаких морфологических изменений. Общее снижение всех значений в конце эксперимента во всех вариантах опыта говорит об отсутствии токсического действия экстракта.
Следует отдельно отметить, что исследования влияния токсикантов на клетки крови африканского клариевого сома проводились многими исследователями [21–23], однако в литературе отсутствуют данные о нормативных значениях количества ядерных нарушений клеток крови. Авторы ссылаются на собственные контрольные значения микроядер в клетках крови, поэтому количественные нормы
в исследованиях отличаются друг от друга. Так, при изучении токсичности карбофурана (пестицид) на гематологические показатели крови африканских сомов концентрация микроядер не должна была превышать 2 ‰ [21], для фентиона (инсектицид) – 30 ‰ [22], для аскорбиновой кислоты – 10 ‰ [23], поэтому установление «нормы» ядерных аномалий крови африканского клариевого сома требует даль-
нейших исследований.
Отсутствие генотоксического эффекта экстракта Laminariocolax aecidiodes на эукариотические клетки ожидаемо и подтверждается другими исследователями. Так, проведенный ранее анализ генотоксичности неочищенного экстракта бурой водоросли Dictyopteris membranacea на клетках C3A человека микроядерным тестом показал отсутствие хромосомных и геномных нарушений [24]. Генотоксичность бурой водоросли Stoechospermum marginatum исследовали также с помощью теста Эймса и методом ДНК-комет на мышах и не выявили значимых кластогенных эффектов [25].
Заключение
Полученный экстракт из эндофитной водоросли L. aecidioides проявляет цитотоксическое действие на прокариотические клетки Escherichia coli и не оказывает токсического воздействия на эукариотические клетки Clarias gariepinus. Согласно данным микроядерного теста можно предположить благоприятную освещенность для содержания африканского клариевого сома около 2–8 мкмоль/м–2·с–1 (150–600 люкс), а частоту встречаемости микроядер, принятую как отсутствие генотоксического эффекта, в диапазоне 0–30 ‰.
1. Усов А. И., Билан М. И. Фукоиданы – сульфатированные полисахариды бурых водорослей // Успехи химии. 2009. Т. 78. № 8. С. 846–862.
2. Вафина Л. Х., Подкорытова А. В. Новые продукты функционального питания на основе биоактивных компонентов бурых водорослей // Изв. ТИНРО. 2009. Т. 156. С. 348–356.
3. Ferreres F., Lopes G., Gil-Izquierdo A., Andrade P. B., Sousa C., Mouga T., Valentão P. Phlorotannin extracts from fucales characterized by HPLC-DAD-ESI-MSn: ap-proaches to hyaluronidase inhibitory capacity and antioxidant properties // Marine Drugs. 2012. V. 10. P. 2766–2781. DOI:https://doi.org/10.3390/md10122766.
4. Williams D. L. Overview of (1→3)-β-D-glucan im-munobiology // Mediators of inflammation. 1997. V. 6. N. 4. P. 247–250.
5. Cheung N. K. V., Modak S., Vickers A., Knuckles B. Orally administered β-glucans enhance anti-tumor effects of monoclonal antibodies // Cancer Immunology and Immunotherapy. 2002. V. 51 (10). P. 557–564.
6. Fritig B., Heitz T., Legrand M. Antimicrobial pro-teins in induced plant defense // Curr. Opin. Immunol. 1998. V. 10. P. 16–22. DOI:https://doi.org/10.1016/s0952-7915(98)80025-3.
7. van Loon L. C., van Strien E. A. The families of pathogenesis related proteins, their activities, and compara-tive analysis of PR-1 type proteins // Physiol. Mol. Plant Pathol. 1999. V. 55. P. 85–97. DOI:https://doi.org/10.1006/pmpp.1999.0213.
8. Li B., Lu F., Wei X., Zhao R. Fucoidan: structure and bioactivity // Molecules. 2008. V. 13 (8). P. 1671–1695. DOI:https://doi.org/10.3390/molecules13081671.
9. Вищук О. С., Ермакова С. П., Тин Фам Дюк, Шевченко Н. М., Ли Буи Минг, Звягинцева Т. Н. Противоопухолевая активность фукоиданов бурых водорослей // Тихоокеан. мед. журн. 2009. T. 3. C. 83–86.
10. Čmiková N., Galovičová L., Miškeje M., Borotová P., Kluz M., Kačániová M. Determination of Antioxidant, Antimicrobial Activity, Heavy Metals and Elements Content of Seaweed Extracts // Plants. 2022. V. 11. P. 1–19. https://doi.org/10.3390/plants11111493.
11. Cai J., Yang D., Zhang J., Guo J., Jiang L. Evalua-tion of bio-guided fraction from Laminaria japonica as a natural food preservative based on antimicrobial activity // Journal of Food Measurement and Characterization. 2020. V. 14. P. 735–748. https://doi.org/10.1007/s11694-019-00320-3.
12. Ширина Ю. М., Конькова А. В., Файзулина Д. Р., Богатов И. А. Стратегия развития кормопроизводства в условиях санкционной политики // Каспий и глобальные вызовы: материалы Междунар. науч.-практ. конф. (Астрахань, 23–24 мая 2022 г.). Астрахань: Изд-во АГУ, 2022. С. 586–589.
13. Крупнова Т. Н. Биология, распространение, культивирование и воспроизводство бурых водорослей. Фукоиданы – сульфатированные полисахариды бурых водорослей. Структура, ферментативная трансформация и биологические свойства. Владивосток: Дальнаука, 2014. 380 с.
14. Skriptsova A. V. Nitrogen Effect on Water-Soluble Polysaccharide Accumulation in Streblonema sp. (Ectocar-pales, Phaeophyceae) // Marine Biotechnology. 2017. V. 19. P. 410–419. https://doi.org/10.1007/s10126-017-9759-3.
15. Скрипцова А. В., Калита Т. Л. Первая находка бурой эндофитной водоросли Laminariocolax aecidioides (Rosenvinge) A. F. Peters, 1998 в дальневосточных морях России // Биология моря. 2020. Т. 46. № 1. С. 45–52. DOI:https://doi.org/10.31857/S013434752001009X.
16. Котова В. Ю., Манухов И. В., Завильгельский Г. Б. Lux-биосенсоры для детекции SOS-ответа, теплового шока и окислительного стресса // Биотехнология. 2009. № 6. С. 36–45. DOI:https://doi.org/10.1134/S0003683810080089.
17. Абилев С. К., Котова В. Ю., Смирнова С. В., Шапиро Т. Н., Завильгельский Г. Б. Специфические lux-биосенсоры Escherichia coli, содержащие плазмиды pRecA::lux, pColD::lux и pDinI::lux, для детекции генотоксичных агентов // Генетика. 2020. Т. 56, № 6. С. 648–656. DOI:https://doi.org/10.31857/S0016675820060028.
18. Игонина Е. В., Марсова М. В., Абилев С. К. Lux-биосенсоры: скрининг биологически активных соединений на генотоксичность // Экологическая генетика. 2016. Т. 14. № 4. С. 52–62. DOI:https://doi.org/10.17816/ecogen14452-62.
19. Kochetkov N. I., Smorodinskaya S. V., Nikiforov-Nikishin D. L., Klimov V. A., Golovacheva N. A., Nikifo-rov-Nikishin A. L., Grozesku Yu. N. Evaluating possible genotoxicity of three feed additives recommended for aquaculture by using micronucleus test on Danio rerio erythrocytes // Vestnik of Astrakhan State Technical University. Series: Fishing Industry. 2022. V. 3. P. 48–59.
20. Witeska M. Erythrocytes in teleost fishes: a review // Zoology and Ecology. 2013. V. 23 (4). P. 275–281. DOI:https://doi.org/10.1080/21658005.2013.846963.
21. Harabawy A. S. A., Ibrahim A. T. A. Sublethal toxicity of carbofuran pesticide on the African catfish Clarias gariepinus (Burchell, 1822): Hematological, biochemical and cytogenetic response // Ecotoxicology and Environmental Safety. 2014. V. 103. P. 61–67. DOI:https://doi.org/10.1016/j.ecoenv.2013.09.022.
22. Nwani C. D., Somdare P. O., Ogueji E. O., Nwani J. C., Ukonze J. A., Nwadinigwe A. O. Genotoxicity assessment and oxidative stress responses in freshwater African catfish Clarias gariepinus exposed to fenthion formulations // Drug and Chemical Toxicology. 2016. V. 40 (3). P. 273–280. DOI:https://doi.org/10.1080/01480545.2016.1209772.
23. Alimba C. G., Ajiboye R. D., Fagbenro O. S. Die-tary ascorbic acid reduced micronucleus and nuclear abnormalities in Clarias gariepinus (Burchell 1822) exposed to hospital effluent // Fish Physiology and Biochemistry. 2017. V. 43. P. 1325–1335. DOI:https://doi.org/10.1007/s10695-017-0375-y.
24. Akremi N., Cappoen D., Anthonissen R., Verschaeve L., Bouraoui A. Phytochemical and in vitro antimicrobial and genotoxic activity in the brown algae Dictyopteris membranacea // South African Journal of Botany. 2017. V. 108. P. 308–314. https://doi.org/10.1016/j.sajb.2016.08.009.
25. Bello A., Padmanabhan S., Thangamalai R., Lakshmanan K., Nagarajan K. Evaluation of genotoxic effects of methanolic extract of brown seaweed Stoechospermum marginatum // The Journal of Phytopharmacology. 2019. V. 8 (5). P. 226–231. DOI:https://doi.org/10.31254/phyto.2019.8504.



